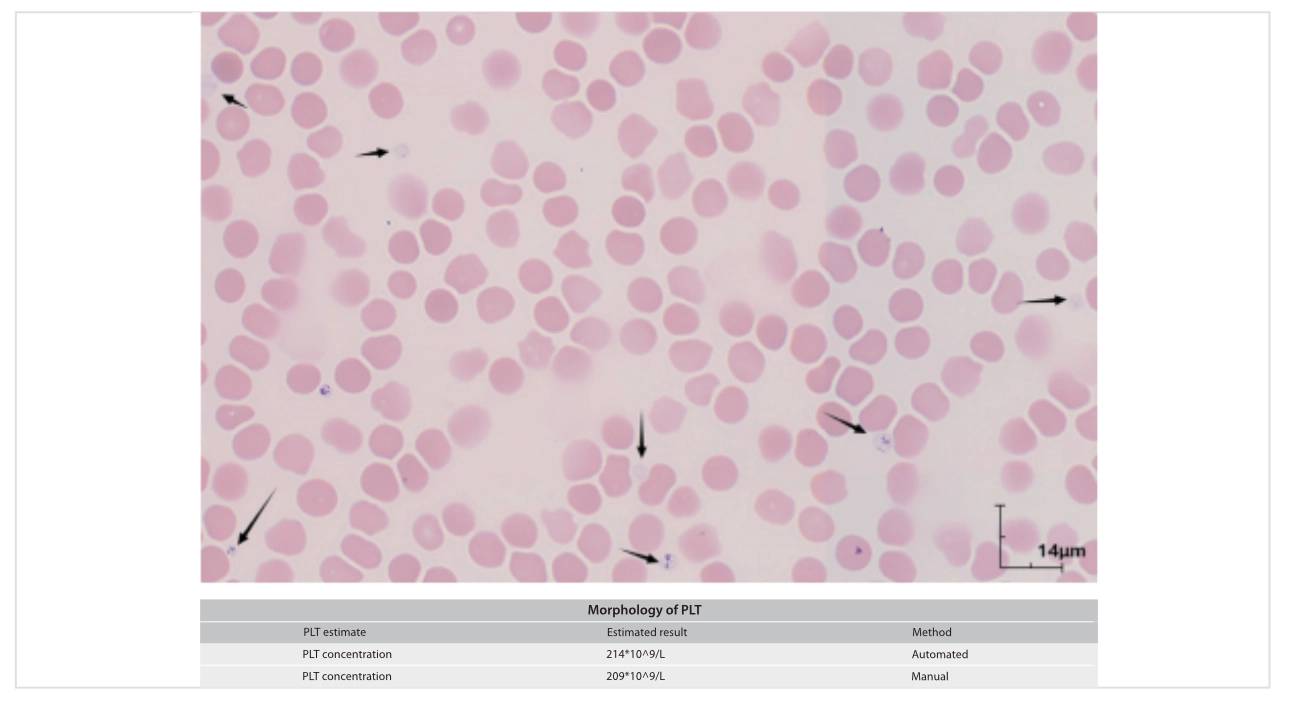
platelet-count-innovation-fig4

Identifying Gray Platelets: Overcoming the Limitations of the Fluorescence Channel
One day, a 59-year-old male patient visited the hospital due to chronic colitis, gastroenteritis, etc. Subsequent pathological diagnosis showed benign colon neoplasm.

The initial CBC results showed: PLT (From impedance channel): 220*109 /L, PLT (From fluorescence channel): 29*109 /L. The difference was significant. The results confused technicians and doctors a lot, as fluorescence-based PLT counting technology is considered as the channel reporting more accurate and reliable PLT results.

Then, a re-examination was conducted. Blood smears were prepared using the peripheral blood of the patient and the smears were subsequently analyzed by the Mindray digital cell morphology analyzer, MC-80. The technician ran the PLT-M mode of the MC-80, and the estimated PLT concentration was reported. The result from the PLT-M mode was consistent with PLT-I result and a large number of gray platelets were observed after scanning.

This is a case of fluorescence-based false PLT count decrease caused by platelet granule deficiency. Platelet granule deficiency is observed in congenital disorders, such as the gray platelet syndrome [1]. The platelets and megakaryocytes have abnormal shapes and the cellular granules are markedly decreased. Since the PLT cellular granules carry a large number of nucleic materials, the lack of these granules leads to the weakening of PLT fluorescence signal, which is a possible cause of PLT-F false low results. However, with the MC-80 and its PLT-M mode, the truth could be disclosed.
Unmatched Reliability and Efficiency: Mindray Digital Cell Morphology Analyzer
Accurate PLT counting results are crucial for PLT transfusion therapies. However, some situations may result in wrong PLT counting results from the automated hematology analyzer, such as EDTA-induced thrombocytopenia or the afore-mentioned gray PLT medical complication [1,2]. Under such circumstances, a blood smear examination is typically performed as reflex testing. However, the conventional manual microscopic examination is time-consuming and labor-intensive.
Mindray digital morphology analyzer, MC-100i, incorporates AI-based digital morphology systems and can be used to address the above-mentioned efficiency challenges. In a recent multicenter study in China, technicians evaluated the accuracy of the MC-100i PLT auto-estimation function, and the ability to detect PLT aggregations at the edges and tail of the blood smear [3].
High correlation with PLT-O
A total of 445 blood samples were selected for analysis, including samples with low PLT (PLT < 100 × 109 /L, n = 173), normal PLT (100 × 109 /L ≤ PLT ≤ 450 × 109 /L, n = 243), and high PLT (PLT > 450 × 109 /L, n = 29). Peripheral blood smears were analyzed using the RBC/PLT mode of MC-100i and verified by morphologists. The PLT auto-estimate was calculated using the RBC count from the hematology analyzers and the PLT/RBC ratio obtained from the MC-100i (PLT auto-estimate = RBC count × PLT/RBC ratio). PLT auto-estimates were compared with PLT-O measured by BC-6800Plus hematology analyzers.

Before verification, the PLT counts estimated by the MC-100i showed a strong correlation with those measured by the PLT-O (r = 0.98). The slope of the regression line was higher than 1, indicating that the MC- 100i estimated slightly more PLTs than the hematology analyzers. The Bland-Altman plot revealed a mean difference of 28 with an upper limit of 126.2 and a lower limit of -70.2. The performance of the MC- 100i on PLT counting was slightly improved after verification.
High sensitivity for PLT clumps
The technicians also investigated the ability of the MC-100i when running PLT-Pro mode to classify PLT clumps using EDTA-dependent pseudo-thrombocytopenia (EDTA-PTCP) blood samples (n = 8) in both EDTA-K2 and sodium citrate-containing vacutainers, and compared their PLT clump counts with the PLT-Pro mode. Using the PLT-Pro mode, the MC-100i automatically classified and counted PLT clumps in EDTA-PTCP blood samples in EDTA-K2 and sodium citrate-containing vacutainers. Several PLT clumps were scanned in EDTA-PTCP samples collected with EDTA-K2 vacutainers after running the PLT-Pro mode.

High efficiency
Lastly, in this study, technicians compared the time required for the analyzer and manual microscopy reviews on 110 slides. Their findings showed that the MC-100i took only 1.34 min to scan one blood smear and verification by morphologists took 0.83 ± 0.28 min. In contrast, manual microscopy review took an average of 8.54 ± 3.61 min per slide.

Remarks: MC-100i is available in China.
Summary
Taken together, the digital morphology analyzers the MC-80 and the MC-100i provide advanced solutions to the challenges in accurate PLT counting and unprecedentedly ease the manual burden of technicians or physicians in the laboratory. Besides, more investigations will be conducted in the future to explore other advanced functions of Mindray digital cell morphology analyzers in assisting with accurate diagnosis.
References:
[1]. Albers, C., Cvejic, A., Favier, R. et al. Exome sequencing identifies NBEAL2 as the causative gene for gray platelet syndrome. Nature Genetics 43, 735–737 (2011). https://doi.org/10.1038/ng.885
[2]. Schuff-Werner, P., Mansour, J., and Gropp, A. Pseudo-thrombocytopenia (PTCP). A challenge in the daily laboratory routine? Journal of Laboratory Medicine 44, 295-304 (2020). https://doi.org/10.1515/labmed-2020-0099
[3]. Hong, J., Wei, X., Wei, Chen. et al. Performance of the digital cell morphology analyzer MC-100i in a multicenter study in tertiary hospitals in China, Clinica Chimica Acta 555, 117801 (2024). https://doi.org/10.1016/j.cca.2024.117801.


